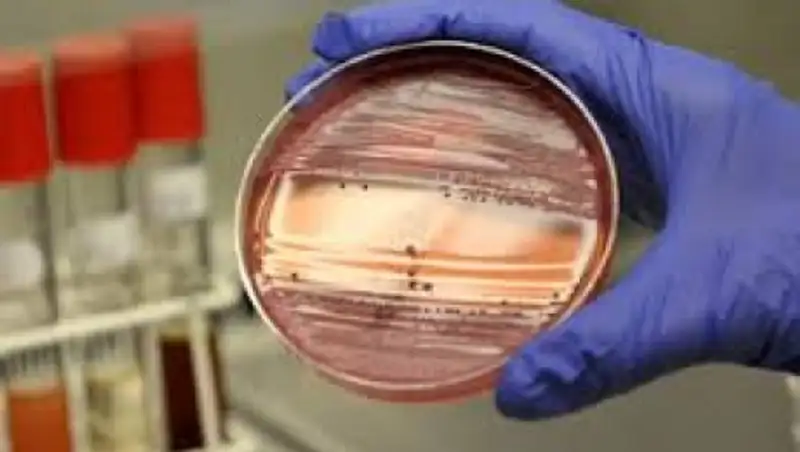
В Северном Казахстане с подозрением на бруцеллёз госпитализированы двое

Павлодарца госпитализировали с подозрением на бешенство
 Zakon.kz
Zakon.kz
Жителя села Ребровка города Аксу 15 мая укусила домашняя собака.
В Павлодарской области госпитализирован 48-летний мужчина с подозрением на бешенство, передает корреспондент pavlodarnews.kz. Об этом агентству сообщил заместитель руководителя областного управления здравоохранения Айдар Сейтказинов.
- Жителя села Ребровка города Аксу 15 мая укусила домашняя собака. Мужчина к медицинской помощи не прибегал, пока у него не появились жалобы на общую слабость. Как оказалось, собака страдала бешенством. 19 июня его госпитализировали с подозрением на болезнь. У пациента обнаружена гидрофобия.На сегодняшний день его состояние тяжелое, - сказал А. Сейтказинов.
По словам заместителя руководителя ведомства, сейчас больной вместе с супругой и ребенком находятся в областной инфекционной больнице. Признаков заболеваемости у членов семьи нет. Заболевание не передается от человека к человеку. Собака застрелена хозяевами.
- В случаях укуса животными необходимо незамедлительно обращаться к помощи врачей, чтобы получить вакцину. Он этого не сделал, поэтому прогнозы не утешительные, - сказал А. Сейтказинов.
Ахмет Кали
Поделитесь новостью
Читайте также
Если вы видите данное сообщение, значит возникли проблемы с работой системы комментариев. Возможно у вас отключен JavaScript